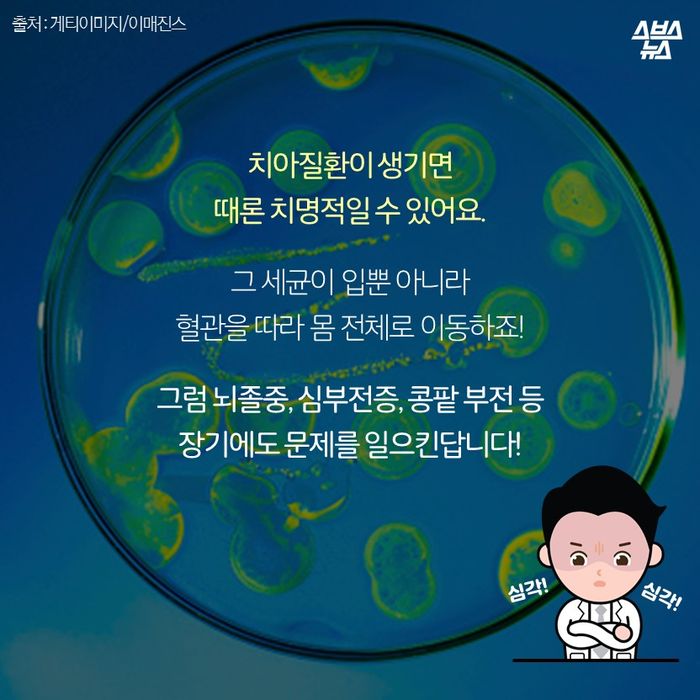
메인이미지  9 : 치아질환이 생기면
때론 치명적일 수 있어요.

그 세균이 입뿐 아니라
혈관을 따라 몸 전체로 이동하죠!

그럼 뇌졸중, 심부전증, 콩팥 부전 등
장기에도 문제를 일으킨답니다!

나 이빨에 철길 깔았샤∼

안녕(멍!) 난 웨슬리에요(멍!) 난 4개월밖에 안 된 아기일 때 이빨이 너무 아팠어요ㅠ

덧니 때문에 입도 잘 안 다물어졌어요..! 밥도 못 먹고, 장난감을 물고 놀지도 못했어요ㅠㅠ

그래서 우리 엄마 몰리가 치아 교정기를 선물해줬어요!

궁금한 건 못 참는 해 리포터 호기심 발-동!! ‘동물 치아 교정’에 대해 샅샅이! 낱낱이! 알아보자고요!

잠까아안!! 웨슬리가 받은 교정은 흔치 않은 방식이에요! 전문가인 저도 처음 봤고요 정식 치료라고 볼 수 없어요. 제대로 된 동물의 교정은 주로 고무줄로 송곳니를 교정합니다.

동물 교정은 사람처럼 미용 목적이 아니에요! 동물은 이빨이 고르지 않으면(부정교합) 먹는 게 힘들어 심각한 문제가 생길 수도 있거든요.

대개 4∼5개월 된 어린 강아지가 이갈이할 때, 유치가 빠지지 않으면 치열이 고르지 않게 되죠. 그래서 이갈이 시기엔 항상 관심을 가져야 해요.
치아질환이 생기면 때론 치명적일 수 있어요. 그 세균이 입뿐 아니라 혈관을 따라 몸 전체로 이동하죠! 그럼 뇌졸중, 심부전증, 콩팥 부전 등 장기에도 문제를 일으킨답니다!

그... 그러면 어떻게 하죠? 허허! 이갈이 시기에는 개 껌과 같은 딱딱한 것을 줘 유치가 잘 빠지도록 해주는 게 좋아요.

그래도 부정교합이 생기면, 동물의 연령, 상태에 따라 교정해야 합니다! 사람처럼 1년 이상 하는 것과 달리 짧게는 1개월, 길게는 6개월밖에 안 걸려요. 생각보다 아주 짧죠? 허허

혹시 우리 귀여운 강아지의 입에서 냄새가 나나요? 그러면 꼭 동물병원 또는 동물치과병원에 데려가야 해요∼!!!




